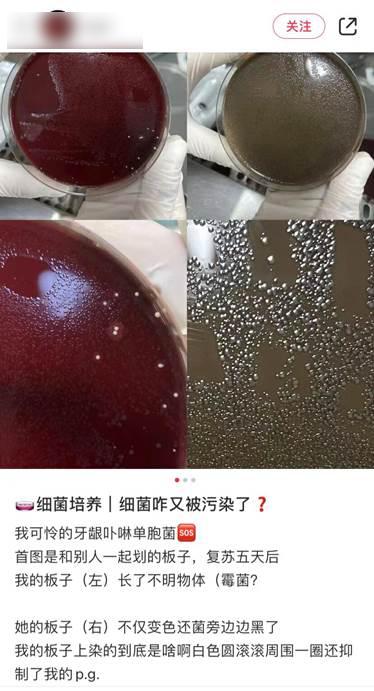

绿毛橙子究竟气疯了多少博士生?
如果你买了一箱水果,里面有一个颜色清奇,长了一身绿毛,这时候你该怎么办?
除了遇事不慌先拍照之外,你还可以发到网上,随机气死几个研究生、博士生。
就像这一箱沃柑中的“抹茶味”橙子一样,网友因为觉得有趣拍了视频发出来,评论区直接炸锅——有一个算一个,全是破防的实验室养菌人。
“这不是坏了,这是实验室梦寐以求的菌……”
原来世界上,竟然还有实验室养菌人这么卑微的群体?
养菌人被PYA的一生
当一个东西因为放得太久而逐渐长出“浓密的毛发”,想了解自然神秘领域的你,也许很想抓一个生物人问问:这是什么菌?
然而事实上,甭管真菌、霉菌、益生菌,在实验室养菌人眼里,统统都只有一个名字:在培养皿就会死菌。
在实验室里,老师千叮咛万嘱咐,还给你找最简单易上手的株,操作到位计划周全,结果一进培养皿,快的三个小时就嘎,运气差一点的,当你觉得“哇不错可以进行下一步”的时候给你嘎。
不仅如此,家庭环境下随机生成的菌落还能气得人直抽抽。
每个养菌菌死的实验人在看到别人家菜篮里毛茸茸的生姜和番茄时,都会在深夜emo,为什么这个遍地生菌的世界容不下自己一个小小的培养皿。
一幕幕惨剧让人不禁怀疑,菌这个东西,属性其实是傲娇吧。
西红柿?不喜欢,但可以长一下。
生姜?勉勉强强吧。
研究生?达咩,我先嘎了。
总之,它也许不厌弃你,但它大概率跟你的学位不兼容。
但天灾打不倒人类的主观能动性。实验室养菌这件事,在一代又一代生物人的努力之下,技术已经变得十分成熟——玄学的那种。
以什么姿势划培养皿平板,用什么样的瓶子摇菌,哪个时间从哪个方向上看它一眼,都是有讲究的。
如果菌还是死了,不信命的科研人只会反思“一定是我哪个姿势没做到位”,而不是单纯的运气差,毕竟前者还留有一丝希望,而后者是漆黑的谷底。
菌:不要跟我讲面子,我不看你们面子。
长此以往,在社交平台上玩梗也就成了网民的基本操作,但凡有家庭菌出落标致,底下一定会cue到研究生。
人比人不如人,菌比菌气死人。你的培养箱是菌落的坟墓,而别人家的茶几底下能开出花来。
在这个充满希望的春天,遍地都能捡到绝望的研究生。
对着培养了好几天愣是不长的菌,实验室养菌人苦酒婆心、语重心长:“就剩你一个兄弟了啊,我都叫你一声哥了,求你快点长。”像极了恨铁不成钢的家长,就差给菌儿子跪下了。
明明跟别人一起划的板子,自己的就是不行。
养细胞染菌,养菌出现噬菌体,总之这些微生物就是自己的房子自己不住,满实验室地偷渡。
论花式嘎的一百种方式,没有比实验室菌更擅长的,要么菌种退化,要么放冰箱依然被真菌污染,要么整体变绿给你看。
来源:抖音@中国戏精大学荣誉博士
最后,培养皿被蘑菇样的霉菌占领,忍着痛煮了,还得忍着不吐。
来源:抖音@ Xback原来在这里呀!
面对实验失败的日常,惨遭微生物PUA的养菌人,只能安慰自己,“实验失败,只是人生中的一点小事”,然后擦干眼泪,再来亿遍。
面对种种艰难困苦,不服输的实验人依然有着跨越一切困难的勇气,虽然代价可能是自己的精神状态。
不过,实验室里的菌种为什么比家庭环境下的难养?真的是研究生不如你家的电冰箱吗?其实不然。
正因为杂菌的生命力好过单一菌种,所以目标菌种才容易嘎。
这就像路边的野花野草之所以茂盛,你家里养啥啥死一样,人家茂盛,正是因为杂嘛!
民间养菌人到底有多大胆
与呕心沥血的精致实验室养菌人不同,民间养菌人可谓艺高人胆大。
如果你看见社交媒体上有人每天抱着笔记如痴如醉地研究微生物,他并不一定是生物专业的学生,更大的可能性是——
养红茶菌做康普茶的,养乳酸菌做酸奶的,养酵母菌做面包的,甚至养醋蛾子酿醋的。
总之是遍布大江南北的民间养菌人。
上流君还记得第一次看见康普茶的震惊:这瓶瓶罐罐里装着的不明物,真的不是巫婆炼的毒药水吗?
来源:自己拍的
康普茶里的漂浮物,便是红茶菌,用红茶和糖发酵而成,曾经风靡过一段时间,被称为“长生不老药”,至于养生效果,只能说可能心诚则灵吧。
来源:自己拍的
有科技手工达人从中看到了 CCTV7都不会教给你的科技致富经,试图手作一种环保新材料。
不过,大部分的养菌人日子也都不太好过,毕竟这个东西傲娇。经常会有做十几二十页笔记,等到它长出厚厚一层,准备收割劳动成果时,一翻面竟然绿了,让人无能狂怒:“哪特么的展青霉啊啊啊啊?!”
醋蛾子这个东西本是无心插柳柳成荫,它原本是古法酿醋的副产品,但在物质匮乏的年代里,却被当成了难得一见的宝贝,吃过的说它吃起来口感好,消暑解腻,现在还被当成养生之物追捧。过去老一辈的讲究人,会一直养着醋蛾子,拿它来手工酿醋。
还有人“大炼”酵母菌,把密恐眼里汗毛倒竖的场面当良辰美景欣赏,做馒头是假,把酵母菌当宠物养才是真。
真的只能感慨一句,养菌人的世界,可能进去了就出不来了。
养菌距离中毒有几步
养菌这事,玩玩可以,看看就罢,最好不要吃。自己养大的东西,不一定就更健康,也可能更危险。
我们一直可以看见各种吃被杂菌污染的发酵食物而中毒的新闻,可见,家庭环境下的此类操作是非常有风险的。
比如号称可以养生的红茶菌,起源于上个世纪的替代疗法时代,与气功和打鸡血是前后脚出生的兄弟,加之科学不发达,民间科普事业刚刚起步时,这种有“官方”背书的、号称“延年益寿”的自制饮料颇受人们欢迎。
随着时代的发展,红茶菌原本已逐渐被淘汰,但近些年乘着“土洋”的东风,却又在社交平台有翻红趋势。
但如今红茶菌的功效早已证明是被夸大了,充其量是一种手工制作的风味饮料,而且在家庭环境下,无法保证其中不携带杂菌,贸然服用是有健康隐患的。
至于醋蛾子,就更不要轻易尝试了。醋蛾子的本质其实就是木醋酸菌产生的菌类纤维,也很容易受到杂菌污染,有人说它有促进消化的功能,但事实却是——纤维素这玩意儿,人体它不消化啊!
而且,也不能排除是吃到了致病菌才窜稀。
养菌最怕的不是失败,而是产生一些奇奇怪怪的东西,比如醋鳗这种靠醋蛾子为食的虫子,前方高能,密恐人士请注意躲避。
而且,菌这东西变态发育之后,不一定长成什么样子。
《走近科学》曾经有一期讲“左海湖”水怪。
最早是当地人在湖里发现一种奇怪的生物,腥臭黏腻,时隐时现,捞上来就碎,还会分裂,内里隐隐有红血丝。当地人害怕极了,都没人敢接近那个湖,并联系了节目组。
节目组来了之后,和相关领域专家研究了上下两集,最后发现,所谓水怪,其实是一种复合微生物。
至于它怎么进到左海湖里长这么大的并不好解释,有可能是当地的环境变化,有可能是外来的。
其中有一种猜测就是,因为当地一些人喜欢养红茶菌,“水怪”可能就是红茶菌混入水体之后,和水中原有的微生物结合产生的。
所以,菌这种东西,不养则已,养了就得负责,不要轻易往自然水体和环境中倾倒,小心超进化之后你承受不住。保险起见,丢弃之前可以放在80℃以上的热水里先煮它十来二十分钟。
如果养菌只是为了观赏,那么时刻提醒保持自己心态平和,当它们一声不吭就嘎过去的时候,血压不要升高。
本文来自微信公众号“网易上流”(ID:heyupflow),作者:Likely,编辑:豌豆 ,36氪经授权发布。